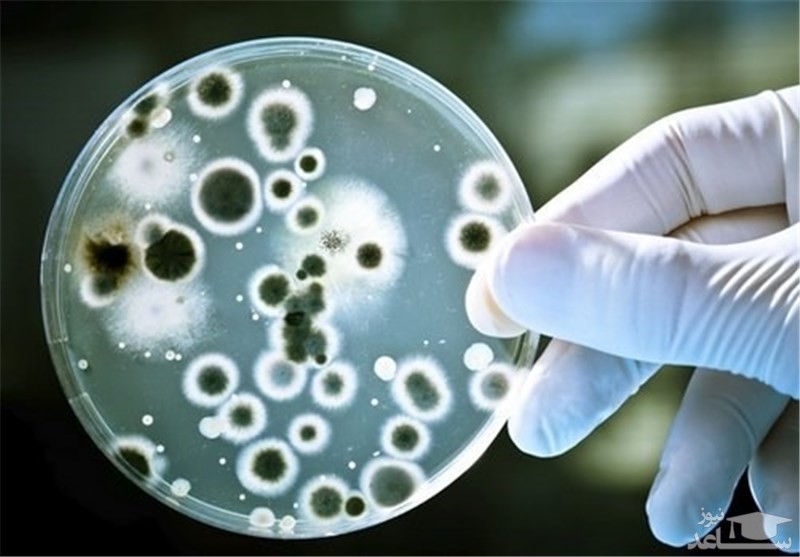
تصویر

ریفلاکس ادراری چیست؟
در حالت طبيعي محل ورود حالبها به مثانه طوري است که امکان پس زدن ادرار داخل مثانه بداخل حالب و از آنجا به داخل کليه وجود ندارد. حتي در حالت پري مثانه، هيچ ادراري از مثانه بطرف بالا نمي رود. در علم پزشکي کليه ها و حالبها را دستگاه ادراري فوقاني و مثانه و مجراي ادرار را دستگاه ادراري تحتاني مي گويند. کلا برگشت ادرار از مثانه به طرف بالا و دستگاه ادراري فوقاني را ريفلاکس ادراري مي گويند. دستگاه ادراري مسئول دفع سموم و آب زيادي بدن است. اگر کليه ها آب زيادي را دفع نکنند، انسان در مايعاتي که مصرف مي کند غرق مي شود.
سيستم يا دستگاه ادراري شامل دو کليه، دو حالب، يک مثانه و يک مجراي ادراري مي باشد. هنگام عبور خون از کليه ها، سموم و آب زيادي بدن توسط کليه ها گرفته مي شود که در مجموع تشکيل ادرار را مي دهند. ادرار تشکيل شده در کليه ها از طريق دو لوله باريک بنام حالب پائين آمده و وارد مثانه مي شود. ادرار در مثانه جمع مي شود و هنگام خالي شدن مثانه، ادرار از طريق مجراي ادرار بيرون مي ريزد. در ريفلاکس، ادرار به طرف بالا به يک يا هر دو حالب برگشت پيدا کرده و گاها وارد يک يا هر دو کليه نيز مي شود. اگر ريفلاکس فقط يک حالب و کليه را گرفتار کند مي گويند يک طرفه است و اگر هر دو حالب و کليه ها را مبتلا سازد مي گويند که دو طرفه است.

دو ریفلاکس ادراری وجود دارد:
- برگشت ادراری اولیه: که مادرزادی است. این بیماری به دلیل نقص در تکامل دریچه های انتهایی لوله حمل کننده ادرار از کلیه به مثانه (لوله حالب) ایجاد می شود. این شایع ترین نوع برگشت ادراری است که معمولاً بلافاصله پس از تولد مشخص می شود.
- برگشت ادراری ثانویه: زمانی اتفاق می افتد که مثانه یا مجرای ادرار مسدود شده باشد و در نتیجه ادرار به سمت کلیه ها بازمی گردد. برگشت ادراری ثانویه در هر سنی ممکن است اتفاق بیفتد و می تواند به دلیل انجام برخی عمل های جراحی، آسیب دیدگی ها، الگوی غیرطبیعی تخلیه مثانه یا عفونت های قبلی که باعث فشار بر مثانه شده است ایجاد شود. این بیماری در کودکانی که نقص های مادرزادی دیگری مانند اسپینابیفیدا دارند بیشتر دیده می شود.
علل بازگشت ادرار
برخی از مشکلاتی که ممکن است موجب رفلاکس ادراری شوند یا به ایجاد آن کمک کنند عبارتند از:
- مشکلات جسمی (ناهنجاری های مادرزادی) کلیه که در هنگام تولد وجود دارد
- مشکلات جسمی (اختلالات مادرزادی) مثانه و خروجی مثانه
- سنگ مثانه
- ضربه و فشار یا آسیب به مثانه
- تورم موقت بعد از جراحی هایی مانند پیوند کلیه
علائم رفلاکس ادراری
ریفلاکس ادرار هیچ نشانه ای ندارد اما می تواند باعث:
- احساس سوزش هنگام دفع ادرار
- تمایل به تکرر ادرار حتی اگر فقط چند قطره باشد
- ادرار خونین و بودار
- درد در قسمت پایین بدن
- دل درد
- بی اختیاری ادرار در روز یا طول شب
- تب
- تغذیه ضعیف، استفراغ و تحرک پذیری
- شدت ریفلاکس ادراری
پزشکان شدت ریفلاکس ادراری را با توجه به نوع ریفلاکس مشخص می کنند. در موارد خفیف ادرار تنها به حالب بازگشت می کند که ریفلاکس ادراری درجه یک است. موارد شدیدتر شامل تورم شدید کلیه (هیدرونفروز) و چرخش حالب است که نوع درجه دو است.
عوامل خطر ریفلاکس ادراری
عوامل خطر برای ریفلاکس ادراری عبارتند از:
- نژاد: به نظر می رسد خطر ابتلا به ریفلاکس ادراری در افراد سفیدپوست بیشتر است.
- جنسیت: به طور کلی دختران دو برابر پسران در معرض خطر ابتلا به این وضعیت هستند اگرچه ریفلاکس ادراری مادرزادی در پسران شایع تر است.
- نوزادان و کودکان بالای 1 سال نسبت به کودکان بزرگ تر بیشتر احتمال دارد به ریفلاکس ادراری مبتلا شوند.
- سابقه خانوادگی: ریفلاکس ادراری اولیه معمولاً به نسل های بعدی منتقل می شوند. اگر هرکدام از این علائم را دارید باید به پزشک مراجعه کنید تا آزمایشات ساده ای برای رفلاکس ادرار انجام شود.

تشخیص ریفلاکس ادراری
برگشت ادراری زمانی که بیمار به عفونت مجرای ادرار دچار می شود مورد توجه قرار می گیرد. پزشک در مورد سابقه علائم کودک سؤالاتی پرسیده و وی را معاینه می کند.
درصورت احتمال ابتلا به عفونت ادراری، پزشک دستور انجام آزمایش های زیر را می دهد:
- کشت ادرار برای بررسی عفونت ادراری
- سونوگرافی از کلیه: در این آزمایش با استفاده از امواج صوتی سایز و شکل کلیه ها مورد ارزیابی قرار می گیرد. با این آزمایش می توان پی به وجود عارضه برگشت ادراری برد.
- سیستواورتروگرام (سیستوگرام): که پس از این که عفونت ادراری درمان شد انجام می شود. با این آزمایش می توان وجود برگشت ادراری را تشخیص داده و میزان شدت آن را مشخص کرد. برای انجام سیستوگرام حین ادرار، عکس برداری به وسیله اشعه ایکس از مجرای ادرار هم انجام می شود. مثانه با رنگ پر می شود و از آن در زمان پر بودن و پس از خالی شدن عکس گرفته می شود.
- برگشت ادراری می تواند از والدین به کودکان به ارث برسد. اگر یکی از کودکان شما به برگشت ادراری مبتلا شده باشد باید از پزشک بخواهید که فرزندان دیگرتان را برای وجود احتمالی بیماری برگشت ادراری معاینه کند. بررسی و معاینه خواهران و برادران فرد مبتلا به برگشت ادراری بسیار مفید است به خصوص اگر فرزندان دیگر شما به عفونت ادراری هم مبتلا شده باشند. پزشک ممکن است دستور انجام آزمایش سیستوگرام را برای نوزاد متولد شده ای که خواهر و برادر مبتلا به رفلاکس ادراری بدهد؛ اما متخصصین با انجام این آزمایش برای کودکان موافق نیستند به دلیل این که باید شی ای وارد بدن آنها شود.

درمان ریفلاکس ادراری
برگشت ادراری خفیف معمولاً تا زمانی که کودک به 5 سالگی می رسد به طور کامل برطرف می شود.
در صورتی که به درمان نیاز باشد، غالباً آنتی بیوتیک هایی مانند آموکسی سیلین یا تری متوپرین – سولفامتوگزال تجویز می شوند. آنتی بیوتیک ها از گسترش عفونت جلوگیری کرده و آن را درمان کرده و احتمال ابتلا به زخم هایی که باعث آسیب دیدگی کلیه می شوند را کاهش می دهند. ممکن است نیاز باشد که کودک به طور مرتب آنتی بیوتیک مصرف کند. پزشک ممکن است کودک را برای وجود علائم دیگر عفونت مجرای ادرار با دقت و مرتباً معاینه کرده و زمانی که عفونت در حال شکل گیری بود، مصرف آنتی بیوتیک را تجویز کند. پزشک ممکن است برای تشخیص وجود باکتری در ادرار بیمار، دستور انجام مکرر آزمایش ادرار را بدهد.
بسیاری از تحقیقات در مورد استفاده طولانی مدت از آنتی بیوتیک برای درمان عفونت مجرای ادرار هشدار داده اند. این تحقیقات نشان می دهند که مصرف طولانی مدت آنتی بیوتیک بر آسیب دیدگی کلیه ها تأثیری نداشته یا تأثیر آن ناچیز است. همچنین استفاده طولانی مدت آنتی بیوتیک باعث می شود که کودک به آنتی بیوتیک مقاوم شود یعنی مصرف آنتی بیوتیک برای وی مؤثر واقع نشود و مدت بیماری وی را طولانی تر کرده و مصرف داروهای قوی تر را اجتناب ناپذیر کند.
سخن پایانی
اگر کودک شما دارای ریفلاکس شدید یا عفونت های مکرر باشد، ممکن است نیاز به عمل جراحی برای عمل دریچه بین مثانه و مدفوع باشد. اما این تنها راهکار آخر است و احتمال دارد که نوزاد شما به آن نیاز نداشته باشد جهت اینکه از این موضوع اطمینان حاصل کنید، حتما به یک پزشک متخصص کودک مراجعه نمائید.











































